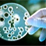

Health Packages
We are providing good packages
Over the last two decades, there have been tremendous technological advances, in the field of diagnostic healthcare which have resulted in new and innovative modalities that are focused on prevention and early detection of disease. At Nandi, we believe that prevention is the best cure and that periodic health check ups are essential for individuals to monitor their health status and take appropriate health and lifestyle precautions.We offer a wide range of preventive health check packages, based on the age, gender and medical history of the patient including.
- All types of Master Health Checkup and Pre employment checkups.

Connect with facebook
Follow on twitter
Sharing on Google+
Share videos on YouTube
Connect with linkedin